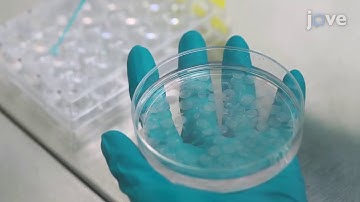
Assessment of the Cytotoxic and Immunomodulatory Effects of Substances in Human

⬇ DOWNLOAD NOW
Kalau muncul iklan pop-up, tutup lalu klik tombol kembali
Download lagu SPE June 2021- grA+de - Digital Dull bit Forensic Scanning System - Ron Schmitz, P. Eng, M. Eng. secara gratis hanya untuk keperluan promosi. Dukung artis favorit kamu dengan membeli musik original di iTunes atau platform resmi lainnya.
 Melanie Vritschan ICAACT Preliminary RF-scanning London
Melanie Vritschan ICAACT Preliminary RF-scanning London
 HDF Research Spotlight Webinar, Christopher Pearson, 2021-06-22
HDF Research Spotlight Webinar, Christopher Pearson, 2021-06-22
 Jörg Enderlein and Christian Eggeling about Scanning FCS
Jörg Enderlein and Christian Eggeling about Scanning FCS
 Best Demo Award - BMVC 2012
Best Demo Award - BMVC 2012
Assessment of the Cytotoxic and Immunomodulatory Effects of Substances in Human
Assessment of the Cytotoxic and Immunomodulatory Effects of Substances in Human
 Sampling for Forensic Practitioners Session 2 - Spring 2022
Sampling for Forensic Practitioners Session 2 - Spring 2022
 A. Biedermann & K. Kotsoglou: Evidence & Proof (...) of scientific evidence in criminal proceedings
A. Biedermann & K. Kotsoglou: Evidence & Proof (...) of scientific evidence in criminal proceedings
 Analyzing Digital Evidence in Digital Forensics (9 Minutes)
Analyzing Digital Evidence in Digital Forensics (9 Minutes)